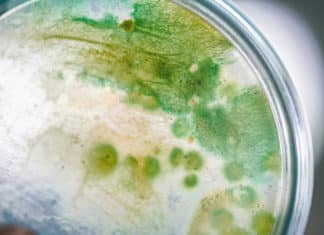
Estuarine Bacteria Eat Centuries Old Food – Metabolism Found To Be 1 Million Times Slower Estuarine Bacteria Metabolism 1 Million Times Slower - Eat Centuries Old Food

Meet New Evolving Superbug That Thrives On Sugary Western Diets!
New Evolving Superbug found to cause diarrhea thrives on the sugar-rich Western diet, according to a new study.
Nitin Kumar, a senior bioinformatician at the...
CRISPR Tweaked Neurons Empowers Scientists For Better Study Of Brain Diseases
Special Version of CRISPR Tweaked Neurons For Brain Disease Study
The first successful merger of stem cell-derived cell types and CRISPR screening technologies
A team of...
Scientists Successful In Reversing Ageing Process In Rat Brain Stem Cells
Successful Reverse Aging Process in Rat Brain Stem Cells
New ways to reverse older cells to Younger!
A new study that is published yesterday in Nature,...
Dog Detectives Detect Pathogenic Bacteria Causing Lung Infection
Dog Detectives detect the pathogenic bacteria that cause lung infections in Cystic Fibrosis (CF) patients. These Sniffer Dogs are specially trained to detect ultra-low...
Biotecnika Times – Newsletter 16.08.2019 – CSIR NET Exam Results, 20+...
Biotecnika Times - CSIR NET Exam Results, 20+ Govt NIF Job
CSIR NET June 2019 Results Declared – Check JRF & LS Rank List
The wait...
CSIR NET June 2019 Results Declared – Check JRF & LS...
CSIR June 2019 Results Declared - Check CSIR NET JRF & LS Rank List
The wait is finally over! CSIR NET June 2019 Exam Results...
Rewiring Damaged Heart Tissues Via Carbon Nanotube Fibers
Rewiring Damaged Heart Tissues Via Carbon Nanotube Fibers
Carbon Nanotube Fibres which are thin and flexible have now proven to bridge damaged heart tissue and...
DST AWSAR Program – Share Your Research Story & Win Cash...
DST AWSAR Program - Share Your Research Story & Win Cash Prize
The call for entries for the DST AWSAR Program has been announced. AWSAR...
Virtual R&D Cancer Research Center
Virtual R&D Cancer Research Center - A Joint Venture by Boehringer & MD Anderson Cancer Center
German pharma Boehringer Ingelheim and also The University of...
Remembering Walter Munk – The Einstein Of The Ocean
Walter Munk - Remembering The Einstein Of The Ocean.
Voice of Biotecnika - Episode No 44
"People should treat the oceans like we do anything else...
New Experimental Drugs Against Ebola Virus, Saving Lives in Congo
These Two Experimental Drugs Against Ebola Virus are successful in Blocking this deadly virus.
According to a report, More than 1,800 people have died in...
Estuarine Bacteria Eat Centuries Old Food – Metabolism Found To Be...
Estuarine Bacteria Metabolism 1 Million Times Slower - Eat Centuries Old Food
Just imagine having a metabolic rate of 1 million times slower than another...
Cyborg Organoids For Viewing Early Stages Of Organ Development
Cyborg Organoids For Viewing Early Stages Of Organ Development
What does happen in the early days of organ development? How do cells or tissues organize...
Biotecnika Times – Newsletter 14.08.2019 – Govt Space Center Life Science...
Biotecnika Times - Govt Space Center Life Science Job, Accenture Latest
Govt Space Application Centre - NESAC Life Science R&D Job
Govt Space Application Centre -...
Manipulation of Brain Cells Now Possible Using Smartphones
Manipulation of Brain Cells can be achieved by using a tiny implant and a smartphone, a new technique developed by Scientists.
A team of researchers...